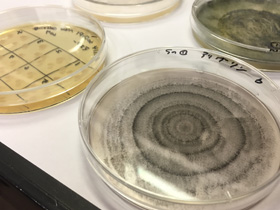
研究室の様子7

メンバー
教授

菅野靖史
プロフィール
- 博士(工学)東京工業大学
- 専門
- 応用微生物学、タンパク質工学
- 所属学会
- 米国微生物学会、日本農芸化学会、米国生化学分子生物学会、日本生化学会など
- 座右の銘
- 一意専心, Time and tide wait for no man.
略歴
- 1986年3月
- 慶応義塾大学理工学部化学科卒業
- 1988年3月
- 東京工業大学大学院総合理工学研究科化学環境工学専攻博士前期課程修了
- 1988年4月
- 日本たばこ産業株式会社入社 海水総合研究所、生命科学研究所、本社技術調査室勤務
この間、東京工業大学より博士(工学)取得
- 1996年3月
- 同社退社
- 1996年4月
- 東京工業大学資源化学研究所 助手
- 2005年4月
- 同助教
- 2009年10月
- 同准教授
- 2011年9月
- Visiting associate professor (University of British Columbia, Canada)
- 2012年4月
- 日本女子大学理学部物質生物科学科 教授
- 2022年4月
- 日本女子大学理学部化学生命科学科 教授 現在に至る
助教
青木綾子
プロフィール
- 博士(農学)東京大学
- 専門
- 微生物機能学、食品免疫学
- 所属学会
- 日本農芸化学会、日本食品免疫学会、日本栄養・食糧学会
略歴
- 2011年3月
- 東京大学大学院農学生命科学研究科応用生命化学専攻博士課程修了
- 2011年4月
- 東京大学大学院農学生命科学研究科農学特定研究員
- 2012年8月
- 北海道大学大学院農学研究院特任助教
- 2013年10月
- 農研機構畜産草地研究所特別研究員
- 2014年4月
- 農研機構畜産草地研究所任期付研究員
- 2015年4月
- 東京大学大学院農学生命科学研究科特任助教
- 2018年4月
- 日本女子大学家政学部食物学科日本学術振興会特別研究員-RPD
- 2022年4月
- 農研機構畜産研究部門日本学術振興会特別研究員-RPD
- 2026年4月
- 日本女子大学理学部化学生命科学科助教 現在に至る
修士・学部・学術研究員
M2
- 花澤美星
- 酢酸菌が生産するDyPとエンカプスリンの役割とは
- DyP、エンカプスリンKomagataeibacter xylinus、セルロース
- 元廣愛華
- 子嚢菌Trichoderma atroviride SLAH2135-2株由来DyPの性質
- DyP、子嚢菌、クラスPTrichoderma atroviride
- 山田雛子
- 土壁材の強度と粘りに関与する微生物の探索
- 土壁、建築材料、枯草菌、滑走細菌、16s DNA解析
B4
- 静間 葵
- バクテリアルセルロースの生産研究
- Komagataeibacter xylinus
- 島 陽菜
- バクテリアルセルロースの生産研究
- Komagataeibacter xylinus
- 中島萌子
- メラニン分解に寄与する白色腐朽菌由来タンパク質の同定
- メラニン分解、白色腐朽菌、Ceriporia lacerata
学術研究員
- 菅原佳奈子
- 細菌が生産するセルロースナノファイバーの生成メカニズムの解明
- セルロースナノファイバー、膜タンパク質、ターミナルコンプレックス、セルロースシンターゼ
- 吉田 徹
- セルロース合成酵素複合体の構造解明
- 酢酸菌、セルロース合成酵素、クライオ電子顕微鏡
研究室の様子
![]() |
![]() |
![]() |
![]() |
![]() |
![]() |
![]() |
![]() |
![]() |